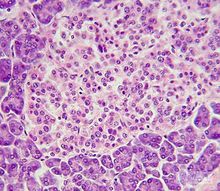
顯微鏡下的胰島 beta 細胞

發現過程
顯微鏡下的胰島 beta 細胞
顯微鏡下的胰島 beta 細胞胰島素於1921年由加拿大人F.G.班廷和C.H.貝斯特首先發現。1922年開始用於臨床,使過去不治的糖尿病患者得到挽救。中國科學院腎病檢測研究所主治直至80年代初,用於臨床的胰島素幾乎都是從豬、牛胰臟中提取的。不同動物的胰島素組成均有所差異,豬的與人的胰島素結構最為相似,只有B鏈羧基端的一個胺基酸不同。80年代初已成功地運用遺傳工程技術由微生物大量生產人的胰島素,並已用於臨床。
1955年英國F.桑格小組測定了牛胰島素的全部胺基酸序列,開闢了人類認識蛋白質分子化學結構的道路。1965年9月17日,中國科學家人工合成了具有全部生物活力的結晶牛胰島素,它是第一個在實驗室中用人工方法合成的蛋白質,稍後美國和聯邦德國的科學家也完成了類似的工作。
70年代初期,英國和中國的科學家又成功地用X射線衍射方法測定了豬胰島素的立體結構。這些工作為深入研究胰島素分子結構與功能關係奠定了基礎。人們用化學全合成和半合成方法製備類似物,研究其結構改變對生物功能的影響;進行不同種屬胰島素的比較研究;研究異常胰島素分子病,即由於胰島素基因的突變使胰島素分子中個別胺基酸改變而產生的一種分子病。這些研究對於闡明某些糖尿病的病因也具有重要的實際意義。
第一代胰島素-動物胰島素
1921年弗雷德里克·班丁(Frederick Banting)與約翰·麥克勞德(John Macleod)合作首次成功提取到了胰島素,不同種族哺乳動物(人、牛、羊、豬等)的胰島素分子的胺基酸序列和結構稍有差異,其中豬胰島素與人的最為接近。動物胰島素是最早套用於糖尿病治療的胰島素注射製劑,一般是豬胰島素,豬胰島素與人胰島素存在1至4個胺基酸的不同,因此容易發生免疫反應,注射部位皮下脂肪萎縮或增生,胰島素過敏反應,並且由於其免疫原性高,容易反覆發生高血糖和低血糖,容易出現胰島素抵抗。
第二代胰島素-人胰島素
20世紀80年代,人們通過基因工程(重組DNA)(轉基因)酵母(啤酒酵母.畢赤酵母或漢遜酵母)或重組中國倉鼠卵巢細胞(CHO)表達出高純度的合成人胰島素,其結構和人體自身分泌的胰島素一樣。
對比動物胰島素,人胰島素較少發生過敏反應或者胰島素抵抗,所以皮下脂肪萎縮的現象也隨之減少;由於人胰島素抗體少,所以注射量比動物胰島素平均減少30%;人胰島素的穩定性高於動物胰島素,常溫25℃左右常溫可保存人胰島素4周。
在起效時間、峰值時間、作用持續時間上不能模擬生理性人胰島素分泌模式。需在餐前30分鐘注射、有較高的夜間低血糖風險。
第三代胰島素-胰島素類似物
20世紀90年代末,在對人胰島素結構和成分的深入研究中發現,對肽鏈進行修飾:利用基因工程技術,改變胰島素肽鏈上某些部位的胺基酸組合;改變等電點;增加六聚體強度;以鈷離子替代鋅離子;在分子中增加脂肪酸鏈,加大與白蛋白的結合,均有可能改變其理化和生物學特徵,從而可研製出更適合人體生理需要的胰島素類似物(insulinsimilitude)。胰島素類似物可緊臨餐使用,也稱為餐時胰島素或速效胰島素。
品種分類
來源:胰島素合成的控制基因在第11對染色體短臂上。基因正常則生成的胰島素結構是正常的;若基因突變則生成的胰島素結構是不正常的,為變異胰島素。在β細胞的細胞核中,第11對染色體短臂上胰島素基因區DNA向mRNA轉錄,mRNA從細胞核移向細胞漿的內質網,轉譯成由105個胺基酸殘基構成的前胰島素原。前胰島素原經過蛋白水解作用除其前肽,生成86個胺基酸組成的長肽鏈——胰島素原(45343345)。胰島素原隨細胞漿中的微泡進入高爾基體,經蛋白水解酶的作用,切去75、55、6075三個精氨酸連線的鏈,斷鏈生成沒有作用的C肽,同時生成胰島素,分泌到B細胞外,進入血液循環中。未經過蛋白酶水解的胰島素原,一小部分隨著胰島素進入血液循環,胰島素原的生物活性僅有胰島素的5%。
胰島β細胞中儲備胰島素約200U,每天分泌約40U。空腹時,血漿胰島素濃度是5~15μU/mL。進餐後血漿胰島素水平可增加5~10倍。
1、動物胰島素:從豬和牛的胰腺中提取,兩者藥效相同。
1、超短效:注射後15分鐘起作用,高峰濃度1-2小時(皮下)。(例如門冬胰島素、賴脯胰島素)
2、短效(速效):注射後30分鐘起作用,高峰濃度2-4小時,持續5-8小時(皮下、肌內、靜注)。(如普通胰 島素、正規胰島素)
3、中效:注射後2-4小時起效,高峰濃度6-12小時,持續24-28小時(皮下)。(如低精蛋白鋅胰島素)
4、長效:注射後4-6小時起效,高75527兩種。(精蛋白鋅胰島素)
5、超長效:注射後3-6個小時起效,維持時間為6-24小時(皮下)。(地特胰島素、甘精胰島素)
6、預混:注射後0.5個小時起效,維持時間為24小時(皮下)。(雙時相胰島素)
結構組成
不同種族動物(人、牛、羊、豬等)的胰島素功能大體相同,成分稍有差異。圖中為人胰島素化學結構。
胰島素由A、B兩個肽鏈組成。人胰島素(Insulin Human)A鏈有11種21個胺基酸,B鏈有15種30個胺基酸,共16種51個胺基酸組成。其中A7(Cys)-B7(Cys)、A20(Cys)-B19(Cys)四個半胱氨酸中的巰基形成兩個二硫鍵,使A、B兩鏈連線起來。此外A鏈中A6(Cys)與A11(Cys)之間也存在一個二硫鍵。
正常值
分子量5734,由A、B兩條肽鏈。
臨床意義
調控循環血中胰島素含量的主要因素為血糖濃度,臨床上常採用葡萄糖耐量實驗(OGTT)結合胰島素釋放實驗來了解胰島β細胞的功能。
分泌
胰島素的生物合成速度受血漿葡萄糖濃度的影響,當血糖濃度升高時,β細胞中胰島素原含量增加,胰島素合成加速。
胰島素在胰島β細胞中合成。胰島素的分子量5700,由兩條胺基酸肽鏈組成。A鏈有21個胺基酸,B鏈有30個胺基酸。A-B 鏈之間有兩處二硫鍵相連。
胰島素是與C肽以相等分子分泌進入血液的。臨床上使用胰島素治療的病人,血清中存在胰島素抗體,影響放射免疫方法測定血胰島素水平,在這種情況下可通過測定血漿C肽水平,來了解內源性胰島素分泌狀態。
影響因素
 胰島素
胰島素血漿葡萄糖濃度血漿葡萄糖濃度是影響胰島素分泌的最重要因素。口服或靜脈注射葡萄糖後,胰島素釋放呈兩相反應。早期快速相,門靜脈血漿中胰島素在2分鐘內即達到最高值,隨即迅速下降;延遲緩慢相,10分鐘後血漿胰島素水平又逐漸上升,一直延續1小時以上。早期快速相顯示葡萄糖促使儲存的胰島素釋放,延遲緩慢相顯示胰島素的合成和胰島素原轉變的胰島素。
進食含蛋白質較多的食物進食含蛋白質較多的食物後,血液中胺基酸濃度升高,胰島素分泌也增加。精氨酸、賴氨酸、亮氨酸和苯丙氨酸均有較強的刺激胰島素分泌的作用。
進餐後胃腸道激素增加進餐後胃腸道激素增加可促進胰島素分泌如胃泌素、胰泌素、胃抑肽、腸血管活性肽都刺激胰島素分泌。
自主神經功能狀態迷走神經興奮時促進胰島素分泌;交感神經興奮時則抑制胰島素分泌。
胰島素受體
胰島素在細胞水平的生物作用是通過與靶細胞膜上的特異受體結合而啟動的。胰島素受體為胰島素起作用的靶細胞膜上特定部位,僅可與胰島素或含有胰島素分子的胰島素原結合,具有高度的特異性,且分布非常廣泛。受體是一種糖蛋白,每個受體由α、β各兩個亞單位組成,並由各兩條亞基組成四聚體型受體。α亞單位穿過細胞膜,一端暴露在細胞膜表面,具有胰島素結合位點。β亞單位由細胞膜向胞漿延伸,是胰島素引發細胞膜與細胞內效應的功能單位。胰島素與亞單位結合後,β亞單位中酪氨酸激酶被激活,使受體磷酸化,產生介體,調節細胞內酶系統活性,控制物質代謝。並由各兩條亞基組成四聚體型受體。每種細胞與胰島素結合的程度取決於受體數目與親和力,此二者又受血漿胰島素濃度調節。當胰島素濃度增高時往往胰島素受體數下降,稱下降調節。如肥胖的非胰島素依賴型糖尿病人由於脂肪細胞膜上受體數下降,臨床上呈胰島素不敏感性,稱抵抗性。當肥胖的非胰島素依賴型糖尿病患者經飲食控制、體育鍛鍊後體重減輕時,脂肪細胞膜上胰島素受體數增多,與胰島素結合力加強而使血糖利用改善。此不僅是肥胖的非胰島素依賴型糖尿病的重要發病機制,也是治療中必須減肥的理論依據。
代謝
胰島素是由胰島β細胞受內源性或外源性物質如葡萄糖、乳糖、核糖、精氨酸、胰高血糖素等的刺激而分泌的一種蛋白質激素。
先分泌的是由84個胺基酸組成的長鏈多肽—胰島素原(Proinsulin),經專一性蛋白酶——胰島素原轉化酶(PC1和PC2)和羧肽脢E的作用,將胰島素原中間部分(C鏈)切下,而胰島素原的羧基端部分(A鏈)和氨基端部分(B鏈)通過二硫鍵結合在一起形成胰島素。
成熟的胰島素儲存在胰島β細胞內的分泌囊泡中,以與鋅離子配位的六聚體方式存在。
在外界刺激下胰島素隨分泌囊泡釋放至血液中,並發揮其生理作用。
胰島素的分泌分成兩部分,一部分幫助維持空腹血糖正常而分泌的胰島素,稱為基礎胰島素,另一部分則是為了降低餐後血糖升高、維持餐後血糖正常而分泌的胰島素,稱為餐時胰島素。餐時胰島素的早時相分泌控制了餐後血糖升高的幅度和持續時間,其主要的作用是抑制肝臟內源性葡萄糖的生成。通過該作用機制,血糖在任何時間均被控制在接近空腹狀態的水平;餐後血糖的峰值在7.0 mmol/L以下,並且血糖水平高於5.5 mmol/L的時間不超過30分鐘。1型糖尿病患者在確診糖尿病之前,大部分患者胰島β細胞發生自身免疫性破壞,導致餐時和基礎胰島素分泌均減少。2型糖尿病患者胰島β細胞功能異常進展緩慢,常常表現為外周胰島素抵抗,但是也同時存在胰島素一相分泌減少,因而可以出現空腹血糖正常而餐後血糖升高的情況。最終,餐後血糖水平可達到非糖尿病的生理狀態時的4倍,並且在進餐後血糖升高持續數小時,以至於在下一餐前仍然顯著升高。彌補餐時胰島素分泌不足的胰島素製劑有諾和靈N,胰島素類似物製劑有諾和銳等。基礎胰島素是胰島細胞24小時持續脈衝式分泌的胰島素,主要用於維持空腹血糖水平的正常。美國糖尿病學會(ADA)與歐洲糖尿病學會(EASD)指南均建議,在生活方式干預和口服糖尿病治療後,如果血糖控制仍不滿意,應儘早開始胰島素治療,且首選基礎胰島素與口服降糖藥合用。若此療法仍不能控制血糖,根據該指南的治療線路圖,建議在此基礎上在就餐時再加用速效胰島素。目前用於彌補基礎胰島素不足的製劑主要有基礎胰島素類似物地特胰島素等。
胰島素由胰島素降解酶(Insulin Degrading Enzyme, IDE)降解。胰淀素和β澱粉樣多肽也是IDE的底物。
胰島素的纖維化:經過大量的臨床醫學以及科學研究,胰島素的澱粉樣纖維化與II型糖尿病密切相關。
功能作用
藥理作用
治療糖尿病、消耗性疾病。促進血循環中葡萄糖進入肝細胞、肌細胞、脂肪細胞及其他組織細胞合成糖原使血糖降低,促進脂肪及蛋白質的合成。
生理作用
胰島素的主要生理作用是調節代謝過程。對糖代謝:促進組織細胞對葡萄糖的攝取和利用,促進糖原合成,抑制糖異生,使血糖降低;對脂肪代謝;促進脂肪酸合成和脂肪貯存,減少脂肪分解;對蛋白質;促進胺基酸進入細胞,促進蛋白質合成的各個環節以增加蛋白質合成。總的作用是促進合成代謝。胰島素是機體內唯一降低血糖的激素,也是唯一同時促進糖原、脂肪、蛋白質合成的激素。作用機理屬於受體酪氨酸激酶機制。
調節糖代謝
胰島素能促進全身組織細胞對葡萄糖的攝取和利用,並抑制糖原的分解和糖原異生,因此,胰島素有降低血糖的作用。胰島素分泌過多時,血糖下降迅速,腦組織受影響最大,可出現驚厥、昏迷,甚至引起胰島素休克。相反,胰島素分泌不足或胰島素受體缺乏常導致血糖升高;若超過腎糖閾,則糖從尿中排出,引起糖尿;同時由於血液成份中改變(含有過量的葡萄糖), 亦導致高血壓、冠心病和視網膜血管病等病變。胰島素降血糖是多方面作用的結果:
(1)促進肌肉、脂肪組織等處的靶細胞細胞膜載體將血液中的葡萄糖轉運入細胞。
(2)通過共價修飾增強磷酸二酯酶活性、降低cAMP水平、升高cGMP濃度,從而使糖原合成酶活性增加、磷酸化酶活性降低,加速糖原合成、抑制糖原分解。
(3)通過激活丙酮酸脫氫酶磷酸酶而使丙酮酸脫氫酶激活,加速丙酮酸氧化為乙醯輔酶A,加快糖的有氧氧化。
(4)通過抑制PEP羧激酶的合成以及減少糖異生的原料,抑制糖異生。
(5)抑制脂肪組織內的激素敏感性脂肪酶,減緩脂肪動員,使組織利用葡萄糖增加。
調節脂肪代謝
胰島素能促進脂肪的合成與貯存,使血中游離脂肪酸減少,同時抑制脂肪的分解氧化。胰島素缺乏可造成脂肪代謝紊亂,脂肪貯存減少,分解加強,血脂升高,久之可引起動脈硬化,進而導致心腦血管的嚴重疾患;與此同時,胰島素缺乏會導致機體脂肪分解加強,生成大量酮體,出現酮症酸中毒。
調節蛋白質代謝
胰島素一方面促進細胞對胺基酸的攝取和蛋白質的合成,一方面抑制蛋白質的分解,因而有利於生長。腺垂體生長激素的促蛋白質合成作用,必須有胰島素的存在才能表現出來。因此,對於生長來說,胰島素也是不可缺少的激素之一。
其它功能
胰島素可促進鉀離子和鎂離子穿過細胞膜進入細胞內;可促進脫氧核糖核酸(DNA)、核糖核酸(RNA)及三磷酸腺苷(ATP)的合成。
體內對抗激素
 胰島素
胰島素(1)胰升糖素(胰高血糖素)。由胰島α細胞分泌,在調節血糖濃度中對抗胰島素。胰升糖素的主要作用是迅速使肝臟中的糖元分解,促進肝臟葡萄糖的產生與輸出,
進入血液循環,以提高血糖水平。胰升糖素還能加強肝細胞攝入胺基酸,及因能促進肝外組織中的脂解作用,增加甘油輸入肝臟,提供了大量的糖異生原料而加強糖異生作用。胰升糖素與胰島素共同協調血糖水平的動態平衡。
進食碳水化合物時,產生大量葡萄糖,從而刺激胰島素的分泌,同時胰升糖素的分泌受到抑制,胰島素/胰升糖素比值明顯上升,此時肝臟從生成葡萄糖為主的組織轉變為將葡萄糖轉化為糖元而貯存糖元的器官。
飢餓時,血液中胰升糖素水平顯著上升而胰島素水平下降。糖異生及糖元分解加快,肝臟不斷地將葡萄糖輸送到血液中。同時由於胰島素水平降低,肌肉和脂肪組織利用葡萄糖的能力降低,主要是利用脂肪酸,從而節省了葡萄糖以保證大腦等組織有足夠的葡萄糖供應。
(2)腎上腺素及去甲腎上腺素。腎上腺素是腎上腺髓質分泌的,去甲腎上腺素是交感神經末梢的分泌物。當精神緊張或寒冷刺激使交感神經處在興奮狀態,腎上腺素及去甲腎上腺素分泌增多,使肝糖元分解輸出增多,阻礙葡萄糖進入肌肉及脂肪組織細胞,使血糖升高。
(3)生長激素及生長激素抑制激素。
①生長激素。由腦垂體前葉分泌,它能促進人的生長,且能調節體內的物質代謝。生長激素主要通過抑制肌肉及脂肪組織利用葡萄糖,同時促進肝臟中的糖異生作用及糖元分解,從而使血糖升高。生長激素可促進脂肪分解,使血漿游離脂肪酸升高。飢餓時胰島素分泌減少,生長激素分泌增高,於是血中葡萄糖利用減少及脂肪利用增高,此時血漿中葡萄糖及游離脂肪酸含量上升。
②生長激素抑制激素。由胰島D細胞分泌。生長激素釋放抑制激素不僅抑制垂體生長激素的分泌,而且在生理情況下有抑制胰島素及胰升糖素分泌作用。但生長激素釋放抑制激素本身對肝葡萄糖的產生或循環中葡萄糖的利用均無直接作用。
(4)腎上腺糖皮質激素。腎上腺糖皮質激素是由腎上腺皮質分泌的(主要為皮質醇,即氫化可的松),能促進肝外組織蛋白質分解,使胺基酸進入肝臟增多,又能誘導糖異生有關的各種關鍵酶的合成,因此促進糖異生,使血糖升高。
(5)自由神經功能狀態可能影響胰島素的分泌。
迷走神經興奮時促進胰島素分泌;交感神經興奮時則抑制胰島素分泌。由以上知道,基因區DNA向mRNA轉錄,生成86個胺基酸組成的長肽鏈——胰島素原(Proinsulin)。胰島素原隨細胞漿中的微泡進入高爾基體,經蛋白水解酶的作用,切去31、32、60三個精氨酸連線的鏈,得出以上結果。
胰島素治療
適應症
1型糖尿病患者,由於自身胰島β細胞功能受損,胰島素分泌絕對不足,在發病時就需要胰島素治療,而且需終生胰島素替代治療以維持生命和生活。約占糖尿病總人數5%。2型糖尿病患者在生活方式和口服降糖藥聯合治療的基礎上,如果血糖仍然未達到控制目標,即可開始口服藥物和胰島素的聯合治療。一般經過較大劑量多種口服藥物聯合治療後 HbA1c仍大於7.0%時,就可以考慮啟動胰島素治療。新發病並與1型糖尿病鑑別困難的消瘦糖尿病患者。在糖尿病病程中(包括新診斷的2型糖尿病患者),出現無明顯誘因的體重下降時,應該儘早使用胰島素治療。對於血糖較高的初發2型糖尿病患者,由於口服藥物很難使血糖得到滿意的控制,而高血糖毒性的迅速緩解可以部分減輕胰島素抵抗和逆轉β細胞功能,故新診斷的2型糖尿病伴有明顯高血糖時可以使用胰島素強化治療。還有一些特殊情況下也須套用胰島素治療:圍手術期;出現嚴重的急性併發症或應激狀態時需臨時使用胰島素度過危險期,如糖尿病酮症酸中毒、高滲性高血糖狀態、乳酸酸中毒、感染等;出現嚴重慢性併發症,如糖尿病足、重症糖尿病腎病等;合併一些嚴重的疾病,如冠心病、腦血管病、血液病、肝病等;妊娠糖尿病及糖尿病合併妊娠的婦女,妊娠期、分娩前後、哺乳期,如血糖不能單用飲食控制達到要求目標值時,需用胰島素治療,禁用口服降糖藥。繼發性糖尿病和特異性糖尿病人。
胰島素製劑
胰島素按照來源和化學結構可分為:動物胰島素、人胰島素、胰島素。
類似物:人胰島素如諾和靈系列,胰島素類似物如諾和銳、諾和銳30、諾和平。
按作用時間特點可分為:速效胰島素類似物、短效胰島素、中效胰島素、長效胰島素(包括長效胰島素類似物)和預混胰島素(預混胰島素類似物),常見速效胰島素類似物如諾和銳,長效胰島素類似物如諾和平。臨床試驗證明,胰島素類似物在模擬生理性胰島素分泌和減少低血糖發生的危險性方面優於人胰島素。
胰島素按藥效長短分類:
1、 超短效:注射後15分鐘起作用,高峰濃度1-2小時。
2、短效(速效):注射後30分鐘起作用,高峰濃度2-4小時,持續5-8小時。
4、長效(魚精蛋白鋅胰島素):注射後4-6小時起效,高峰濃度4-20小時,持續24-36小時。
5、預混:即將短效與中效預先混合,可一次注射,且起效快(30分鐘),持續時間長達16-20小時。
市場常見的有30%短效和70%中效預混,和短、中效各占50%的預混兩種。
使用注意
開始胰島素治療後應繼續堅持飲食控制和運動,並加強對患者的宣教,鼓勵和指導患者進行自我血糖監測,以便於胰島素劑量調整和預防低血糖的發生。所有開始胰島素治療的患者都應該接受低血糖危險因素、症狀和自救措施的教育。
胰島素的治療方案應模擬生理性胰島素分泌的模式,包括基礎胰島素和餐時胰島素兩部分的補充。方案的選擇應高度個體化,按照血糖達標為驅動的階梯治療方案,儘早控制血糖平穩達標。
學會自我觀察經常用手指按壓注射部位有無硬結、疼痛感,嚴重時應請教專業醫護人員,打針時要避開這些部位。注射胰島素的人,應自備血糖儀,保證每天自測血糖,了解血糖波動情況,每次將結果記錄下來,以便複查時醫生調整胰島素用量。
注射過量的不良反應
如果在治療中注射胰島素過量,會導致低血糖,中毒較輕時,主要影響植物神經系統,表現為飢餓、眩暈、蒼白、軟弱和出汗,也可有震顫、心前區不適,顏面和四肢麻木、頭痛。當血糖進一步降低時,影響中樞神經系統,出現發音障礙、復視、肌肉震顫、共濟失調,隨後神志昏迷和不同程度的驚厥,這種狀態即所謂胰島素休克,如不及時搶救,即可致死。
注射部位須知
注射胰島素是糖尿病人應該掌握的一項“技術”。除了注射外,部位的選擇也很關鍵,因為合適的注射部位不僅能減少注射的危險,還有助於胰島素的吸收。
腹部:是應優先選擇的部位,因為腹部的皮下脂肪較厚,可減少注射至肌肉層的危險,捏起腹部皮膚最容易,同時又是吸收胰島素最快的部位。應在肚臍兩側旁開3~4指的距離外注射,越往身體兩側皮下層越薄,越容易扎至肌肉層。這個部位最適合注射短效胰島素或與中效混合搭配的胰島素。
另外,大腿外側、上臂外側四分之一部分和臀部也是適合注射胰島素的部位。
大腿外側:只能由前面或外側面進行大腿注射,內側有較多的血管和神經分布,不宜注射。注射大腿時一定要捏起皮膚或使用超細超短型(5毫米)筆用針頭。
上臂外側四分之一部分:此處是最不適合自我注射的部位,因為上臂皮下組織較薄,易注射至肌肉層:自我注射時無法自己捏起皮膚。必須注射上臂時,建議使用超細超短型筆用針頭(5毫米)或由醫護人員及家人協助注射。
臀部:臀部適合注射中、長效胰島素(例如睡前注射的中效胰島素),因為臀部的皮下層較厚,對胰島素的吸收速度慢,這樣更能很好地控制空腹血糖,同時又無需捏起皮膚也無肌肉注射風險。
存放方法
胰島素須保存在10℃以下的冷藏器內,在2℃~8℃溫度的冰櫃中可保持活性不變2~3年,即使已部分抽吸使用的胰島素也是如此。使用時,溫度不超過30℃和小於2℃的地方均可,但必須避開陽光,以防失效。
正在使用中的胰島素,只要放在室內陰涼處就可以了。開瓶使用中的瓶裝胰島素可以放在冰櫃的冷藏室中,保存約3個月。使用中的胰島素筆芯不要和胰島素筆一起放回冷藏室中,可隨身攜帶保存4周。
混濁型胰島素若是被震搖幾個小時或是沒有適當保存時便可能會形成團塊,這時胰島素就應該丟棄。
1、 胰島素因避免高溫和日光直曬。
2、胰島素應保存在2--8℃的冰櫃中,未開啟的胰島素應在保質期前使用。
3、開啟的胰島素放在冰櫃內的保質期一般為1月,註明開啟時間。
4、切記不要把胰島素放在冰櫃的冷凍層,結凍的胰島素不能使用,只能放在冷藏室內。
5、注射前從冰櫃中取出胰島素後在室溫放置20分鐘後注射。
6、安裝了胰島素筆芯的注射筆,請不要在冰櫃內保存,放在陰涼處即可。
7、乘飛機旅行時應將胰島素隨身攜帶,不要放在寄託的行李。
不適宜人群
一般無不適合的人群。
胰島素反應
全身反應
⑴低血糖反應:最常見。多見於Ⅰ型中脆性型或Ⅱ型中重型,特別是消瘦者。一般由於體力活動運動太多,偶或飲食太少、減量、失時或劑量過大。症狀有飢餓感、頭暈、軟弱、出汗、心悸,甚而出現神經症狀,如定向失常、煩躁不安、語無倫次、哭笑無常,有時可更嚴重,甚而昏厥、抽搦、狀似癲癇,昏迷不醒,以致死亡。治程中應教會病人熟知此反應而隨時提高警惕,及早攝食糕餅糖食或糖水以緩解,較重者應立即靜脈注射50%葡萄糖40ml以上,繼以靜脈滴注10%葡萄糖水直至清醒狀態;有時可先注胰高血糖素,每次皮下或肌肉1mg,如低血糖反應歷時較久而嚴重者還可採用氫化可的松,每次100~300mg於5%~10%葡萄糖水中靜滴。當低血糖反應恢復後必須謹慎估計下次劑量,分析病情,以防再發。在多次低血糖症後由於刺激胰島α細胞及腎上腺可發生反應性高血糖(Somogyi效應),由此常導致脆性型,必須儘量避免。
⑵過敏反應:少數病人有過敏反應,如蕁麻疹、血管神經性水腫、紫癜,極個別有過敏性休克。此種反應大致由於製劑中有雜質所致。輕者可治以抗組胺類藥物,重者須調換高純度製劑如單組分人胰島素,由於其胺基酸序列與內源性胰島素相同,且所含雜質極少,引起過敏極罕見,或可改用口服藥。必需時還可採用小劑量多鎰胰島素皮下注射脫敏處理。
⑶胰島素性水腫:糖尿病未控制前常有失水失鈉,細胞中葡萄糖減少,控制後4~6日可發生水鈉滯留而水腫,可能與胰島素促進腎小管回吸收鈉有關,稱為胰島素水腫。
⑷屈光失常:胰島素治程中有時病人感視力模糊,由於治療時血糖迅速下降,影響晶狀體及玻璃體內滲透壓,使晶狀體內水分逸出而屈光率下降,發生遠視。但此屬暫時性變化,一般隨血糖濃度恢復正常而迅速消失,不致發生永久性改變。此種屈光突變多見於血糖波動較大的幼年型病者。
局部反應
⑴注射局部皮膚紅腫、發熱及皮下有小結髮生,多見於NPH或PZI初治期數周內,由於含有蛋白質等雜質所致,改變注意部位後可自行消失,不影響療效。
⑵皮下脂肪萎縮或增生,脂肪萎縮成凹陷性皮脂缺失,多見於女青年及小兒大腿、腹壁等注射部位;皮下組織增生成硬塊,多見於男性臀部等注射部位,有時呈麻木刺痛,可影響吸收,須更換注射部位而保證治療。
抗藥性
很少數病者有胰島素抗藥性,每日胰島素需要量超過200U,歷時48小時以上,同時無酮症酸中毒及其他內分泌病引起的繼發性糖尿病者稱為胰島素抗藥性。此組不包括肥胖、感染、肝病、血色病、白血病、類風濕性關節炎、脂肪萎縮性糖尿病等所致的抗藥性。免疫反應,由於注射胰島素後血液中產生抗胰島素抗體,一般屬IgG類,尤以牛胰島素易於產生。因而,此處的胰島素抗藥性不要與病理生理中的胰島素抵抗相混淆。
處理方案:
①改用單組分人胰島素可明顯減少抗體產生,緩解抗藥性;
②試改用口服抗糖尿病藥物及其相互的聯合;
③在抗體濃度明顯增高的患者,必要時可試服強的松,30mg~40mg/d,分3次服,大多也可於1~2周內使胰島素劑量明顯減少,見效後漸減,停強的松。治程中,須密切觀察病情和血糖,以免在抗藥性消退時發生反覆嚴重的低血糖症。
胰島素治療腎病只能說是降糖的,患者在使用的時候,一定要經常檢測血糖,一旦發現低血糖現象,應該及時調整胰島素用量。

